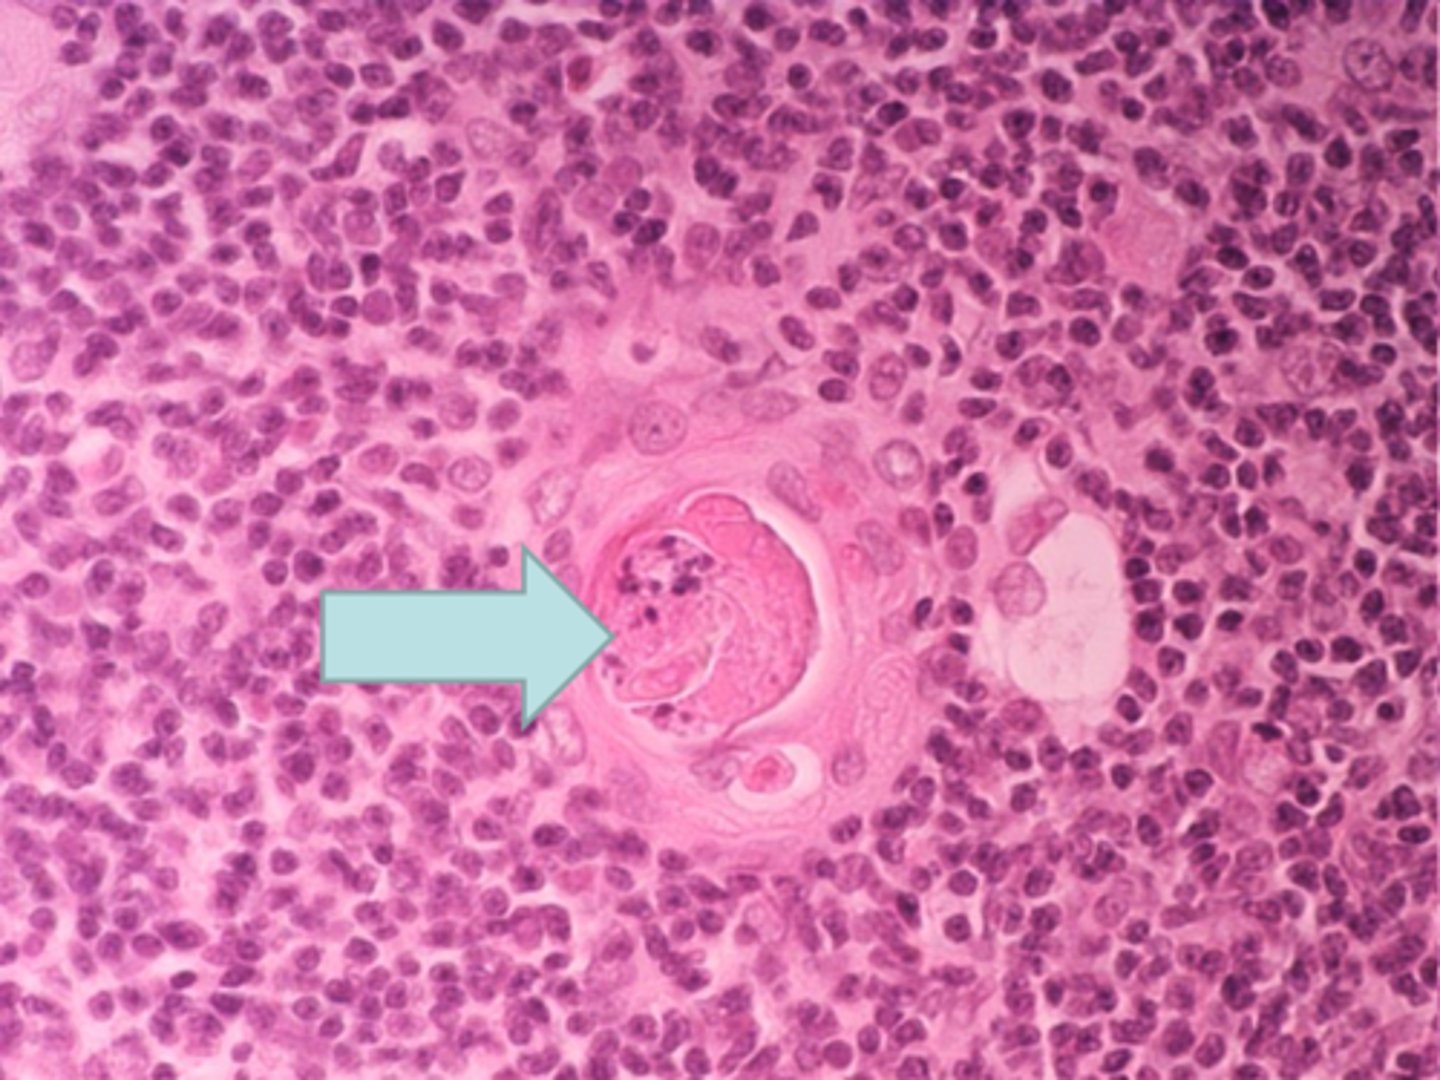
<p>blue arrow Thymus - Hassall´s corpuscle</p>

Histology BCT Practical Exam 2 (Labs 8–13) – Image Identification | Rapid ID | High-Yield | Tri 1
1/600
There's no tags or description
Looks like no tags are added yet.
Name | Mastery | Learn | Test | Matching | Spaced | Call with Kai |
|---|
No analytics yet
Send a link to your students to track their progress
601 Terms
) Primary multilaminar follicle
Identify the follicle

True
T/F: The arrow is at posterior segment of the eye which contains vitreous humor. inner chamber

medium size vein
blue arrow
medium size vein

tunica media is thicker in the artery
Compare tunica medias

tunica intima
yellow arrow
tunica intima

tunica media
green arrow
tunica media

tunica adventitia
red arrow
tunica adventitia

elastic fibers
black areas
elastic fibers

medium size (muscular) artery
ID the tissue
medium size (muscular) artery

aorta
elastic, large, artery with vasovasorum
AKA conducting artery
tissue

tunica media of large vein
yellow arrow
tunica media of large vein

tunica adventitia of large vein
blue line
tunica adventitia of large vein

large vein
ID tissue
large vein

large vein
I: tunica intima
M: tunica media
A: tunica adventitia
V: valve
ID tissue. What are each of the letters?large vein
I: tunica intima
M: tunica media
A: tunica adventitia
V: valve

atria
do atria or ventricles have thinner myocardium?
part of it
is subendocardium part of the endocardium or below it?
primary lymphatic nodule (made of B lymphocytes)
black arrow
primary lymphatic nodule (made of B lymphocytes)

T lymphocytes
red arrow
T lymphocytes

colon: lymphoid nodule
where is this tissue located?
colon: lymphoid nodule

B lymphocytes
(not exposed to pathogen yet)
black arrow
B lymphocytes

T lymphocytes
red arrow
T lymphocytes

Peyer's patches in ileum
collection of secondary lymphatic nodules
ID structure
Peyer's patches in ileum
collection of secondary lymphatic nodules

secondary lymphatic nodule
black arrow
secondary lymphatic nodule

Peyer's patches
black arrow
Peyer's patches

peyer's patches
black arrow
peyer's patches

C: cortex
P: paracortex
MC: medullary cord
MS: medullary sinuses
Label the following letters:
C: cortex
P: paracortex
MC: medullary cord
MS: medullary sinuses:

Cortex containing B lymphocytes
What is in C?
Cortex containing B lymphocytes

Medullary cord of medulla contains lymphocytes and plasma cells
What is in MC?
Medullary cord of medulla contains lymphocytes and plasma cells

Medullary sinuses of medulla contains macrophages and reticular cells
What is in MS?
Medullary sinuses of medulla contains macrophages and reticular cells

lymph node
cortex & paracortex
ID structure
lymph node
cortex & paracortex

T cells
What is in paracortex of lymph node?
Mostly secondary lymphoid nodules but some primary
What is in cortex of lymph node?
trabecula
black arrow
trabecula

lymph node capsule
ID Structure
lymph node capsule

peritrabecular sinus
black arrow
peritrabecular sinus

subcapsular sinus
black arrow
subcapsular sinus

medullary sinuses
black arrows
medullary sinuses

medullary cords
black arrows
medullary cords

blood vessel
black arrow
blood vessel

lymph node medulla
ID structure
lymph node medulla

sinuses
black arrow
sinuses

secondary lymphatic nodule
red arrow
secondary lymphatic nodule

lymph node
ID structure
lymph node

cortex of lymph node
tissue type
cortex of lymph

secondary lymphatic nodule
yellow arrow
secondary lymphatic nodule

trabeculae
black arrow
trabeculae

subscapular sinus
red arrow
subscapular sinus

medullary sinuses
yellow arrow
medullary sinuses

cords of cells
black arrow
cords of cells

medulla of the lymph node
ID structure
medulla of the lymph node

lighter plasma cells
darker B lymphocytes
(primary is only darker B lymphocytes)
How do you know it is secondary lymphatic nodule?
medullary cords
red arrow
medullary cords

spleen
where is this tissue located?
spleen

capsule
C?
capsule

Trabeculae
T?
Trabeculae

white pulp
W?
white pulp

red pulp
R?
red pulp

WBCs
20% of spleen
What does white pulp contain? What percentage of spleen is it?
white pulp
(nuclei are basophilic)
is white pulp or red pulp darker staining (basophilic)?

PAL
periarteriolar lymphatic sheath
blue arrow
PAL
periarteriolar lymphatic sheath

central artery
yellow arrow
central artery

spleen
Where is this tissue?
spleen

central artery
yellow arrow
central artery

PAL
red trianglePAL

trabeculae
blue arrow trabeculae

trabecular artery
yellow arrow trabecular artery

sinusoidal capillary
blue arrow sinusoidal capillary

splenic cord
yellow arrow splenic cord

medulla
yellow arrow medulla

cortex
blue arrow cortex

thymus
where is this tissue? thymus

yellow arrow

medulla containing T lymphocytes
blue arrow medulla containing T lymphocytes

Hassall's corpuscle
red arrow Hassall's corpuscle

thymus
Where is this tissue located? thymus

Thymus - Hassall´s corpuscle
blue arrow Thymus - Hassall´s corpuscle
PALs of red pulp of spleen
black arrow PALs of red pulp of spleen

central artery of spleen
black arrow

trabecluae
black arrows

sinusoidal capillaries
black arrows

Central artery of the spleen
Identify the structure at the arrow?

Trabeculae artery
The arrow is pointing at:

Secondary lymphatic nodule of the lymph node
Identify the structure at the arrow?

It could be found in any of the mentioned blood vessels
The structure at the arrow could be found in which of the following blood vessels?
It could be found in any of the mentioned blood vessels

Endothelium of the endocardium
Identify the layer at the arrow? Endothelium of the endocardium

False
T/F: The arrow is pointing at a venule.

Epicardium (visceral layer of pericardium)
The star is located in which of the following layers of the heart?

Venule
Identify the structure at the arrow?

B Lymphocytes
Identify the majority of cell types in this structure?

Trabeculae of the lymph node
Identify the structure at the arrow?
Trabeculae of the lymph node

Sinusoidal capillary of the spleen
Identify the structure at the arrow?
Sinusoidal capillary of the spleen

T lymphocytes
Thymus
Identify the organ and major types of the cells found in this organ?

True
T/F: This is a large vein since it contains thick tunica adventitia.

Colon
Spleen
Ileum
Which of the following organs have lymphoid (lymphatic) nodules?
Tunica media of a medium size artery
The arrow is pointing at

This is a contracticle cells of the heart
Which of the following statements is not correct about the cell at the arrow?

A) arteriole
Identify the structure at the arrow?

A) adipocytes in pericardium
Identify the cells at the arrow?

C) capillary
Identify the structure at the arrow?

A) Hassall's corpuscle in the thymus gland
Identify the structure at the arrow?
